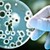
Иде бич по-страшен от рака

През 2050 година устойчивите на антибиотици бактерии ще убиват повече хора от рака
- Редактор: Петя Георгиева
- Коментари: 0

Смъртните случаи, причинени от устойчиви на антибиотици бактерии, до 2050 година ще надхвърлят тези, причинени от рак.
Това заяви турски лекар, цитиран от в. „Дейли сабах“, по време на откриването на форума „Образователна програма за болнично пренасяни инфекции 2019“. Събитието беше организирано съвместно с университета „Хитит“ в централната провинция Чорум.
Професор Серхат Юнал заяви, че болнично пренасяните инфекции могат да имат сериозни последствия и дори да доведат до смърт заради устойчивост към антибиотици, дори в случаи, при които пациентът е приет с леки наранявания или малка инфекция.
„Можем да изгубим млад човек, приет за дребна рутинна интервенция заради неконтролируеми и нелечими инфекции, с които той е влязъл в контакт в болницата. Именно в това се крие големият проблем с антимикробната устойчивост“, посочва професор Юнал.
Според него контролът над инфекциите си остава единственият и най-ефективен начин за борба с резистентността. Юнал отбелязва, че всички болнични служители – от лекарите до администраторите, трябва да работят като екип в борбата със заразите.
Устойчивостта на антибиотици се получава, когато бактерията развива способност да оцелява дори когато е третирана със силни антибиотици, разработени с единствената цел да я убият или да спрат разпространението и разрастването й.
Според изследване, публикувано от Европейската мрежа за наблюдение на антимикробиотичната устойчивост през 2018 година в ЕС и Еврозоната от инфекции, свързани с устойчиви на антибиотици бактерии, са починали 33 000 души на годишна база. В САЩ жертвите на годишна база са 23 000 души, а заразените са над 2 милиона души на година.

Mъж от Цар Калоян получил над 67 000 лева с фалшив ТЕЛК
Тежки камиони рушат компрометираната дига в Николово
Дара: Успехът на "Евровизия" не е Ваш, Филип Киркоров
Чавдар Влъчков: Отрежат ли математическата паралелка в Русе,...
Къде ще учат бъдещите осмокласници в Русе